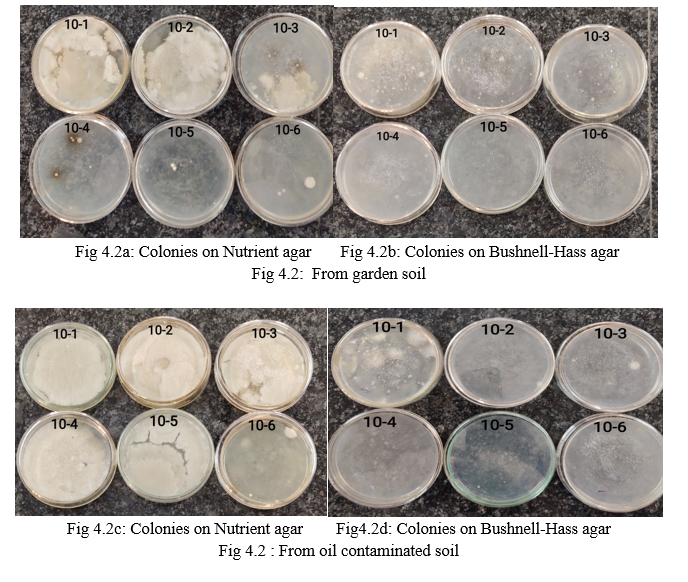

Ijraset Journal For Research in Applied Science and Engineering Technology
Authors: Sudha Sree, Ms. V. Gayatri
DOI Link: https://doi.org/10.22214/ijraset.2021.39341
Certificate: View Certificate
Polysaccharides are important potent molecules with their structural and compositional complexity which led to wide range of applications in various industries. The exopolysaccharides of microbial origin are released in response to extreme environmental conditions for the purpose of survival. The present study focuses on the isolation of exopolysaccharide producing bacteria from the soil sample and oil contaminated soil sample. Screening for the EPS production by the isolates is determined by the dry weight determination of precipitates of EPS and quantitative estimation of glucose content of EPS by Phenol-Sulphuric acid method. In the present study, out of 5 bacterial isolates isolated on screening, Lactobacillus sps and Pseudomonas sps. isolates produced the precipitates of EPS whose dry weight was determined to be 0.09g and 0.17g respectively. Further, glucose concentration of EPS was quantitatively determined. The glucose content of Lactobacillus sps. isolate was 0.1125mg/ml and Pseudomonas sps. isolate is 0.2875mg/ml. The EPS producing isolates were further grown in the presence of carbon sources like Glucose, Lactose, Maltose and Sucrose to determine the best utilizable carbon for their growth. The most utilizable carbon source for maximum growth of EPS producing isolates was determined to be sucrose with 2% concentration. All the 5 bacterial isolates were screened for their ability of antibiotic resistance. The EPS producing isolates, Lactobacillus sps, Pseudomonas sps were found to be resistant towards all the antimicrobial agents owing to the presence of EPS protective layer around their cell wall than non-EPS producing isolates.
I. INTRODUCTION
A. Exopolysaccharides
The polysaccharides are therapeutically potent molecules whose chemical and structural diversity bestow on their diversified roles in microbial ecology,medicine,dairy industry,biofilms, agricultural industry, comestics, nutraceuticals etc (Nwodo et al., 2012).
Polysaccharides from the microbial origin also have been reported to have potential therapeutic applications (Vincent et al., 2000). Recently, a lot of attention is being paid to the microbial exopolysaccharides (EPSs) due to their health benefits and hence,they are being treated as highly potential molecules (De Vuyst et al., 1999). Microbial polysaccharides are generally classified into three categories according to their functions; capsular polysaccharides such as K30 OAntigen, intracellular storage polysaccharides such as glycogen, and exopolysaccharides such as dextran, xanthan, cellulose etc. (Schmid et al., 2015). Prokaryotes (archaebacteria and eubacteria) and eukaryotes (phytoplankton, fungi and algae) can produce exopolysaccharides (Kumar et al., 2007). Exoploysaccharides (EPSs) synthesizing
enzymes are located in cell wall (Huassain et al., 2017). Bacterial exopolysaccharides include dextran, alginate, xanthan, curdlan, cellulose, succinoglycan, glucuronan, colanic acid etc. Bacteria producing exopolysaccharides are Acetobacter spp., Rhizobium meliloti, Pseudomonas aeruginosa, Lactobacillus helveticus, Lactobacillus rhamnosus, Xanthomonas spp., Shigella spp., Escherichia coli, Salmonella spp.,
Enterobacter spp. etc (Ahmad et al., 2015).
The characteristics of Bacterial EPSs are identified by their molecular structure, chemical composition, average molecular weight, conformation of single molecules and their assemblies in case of aggregation process and gel systems (Morris et al., 2011). In case of concentrated solutions, viscosity and viscoelasticity are determined by rheometry (Iijima et al., 2007; Simsek et al., 2009).
EPSs have high molecular weights varying from 10 to 1000 kDa and they may be either homopolymeric or heteropolymeric in composition (Nwodo et al., 2012). Mostly EPSs consist of carbohydrates and proteins, but nucleotide, humic substances and lipids are also included (Fleming, 2000).
a. Micro-organisms producing EPS: EPSs producing microorganisms include various genera of algae, fungi and bacteria that may be thermophilic, mesophilic, and halophilic. Famous mesophilic bacteria include Lactic Acid Bacteria (LAB). Other mesophilic bacteria are Escherichia spp., Bacillus spp., Pseudomonas spp., Streptococcus spp., Acetobacter spp., Aureobasidium spp., Escherichia spp., and Lactobacillus spp. Thermophilic archaebacteria are Sulfolobus, Thermococcus and Archaeoglobus fulgidus (Nicolaus, et al., 1993; Rinker & Kelly, 1996; Lapaglia & Hartzell, 1997). Numerous thermophilic bacteria act as excellent EPSs producers such as Geobacillus thermodenitrificans, Bacillus thermantarcticus and Bacillus licheniformis. Methanococcus jannaschii, Thermotoga maritima and Geobacillus tepidamans V264 co-cultures produce a huge amount of EPSs (Kambourova et al., 2009). Many halophilic Archaea such as Haloferax, Halococcus, Natronococcus, Haloarcula and Halobacterium also produce EPSs (Antón et al., 1988; Nicolaus et al., 1999; Paramonov, 1998).
2. Classification of EPS: The microbial exopolysaccharide from lactic acid bacteria can be divided into two major groups such as homoexopolysaccharides and hetero-exopolysaccharides. An overview on the classification of lactic acid bacteriaderived exopolysaccharides has been summarized in Figure 1. In microbial cells, hetero- and some homopolysaccharides are synthesized and secreted into the extracellular environment. Although synthesis of homopolysaccharide occurs outside the cells after specific enzymes are exuded (Donota et al., 2012). Homo - exopolysaccharides are consisting of single type of monosaccharide such as α-D-glucans, β-D-glucans, fructans, and polygalactans, whereas, hetero exopolysaccharides are formed of different types of monosaccharides including D-glucose, D-galactose, L-rhamnose, and their derivatives (Mayo et al., 2010; Harutoshi, 2013).

Homo exopolysaccharides are the chemical structures of single type of monosaccharide, whereas, hetero-exopolysaccharides contain regular repeating units of 3-8 different carbohydrate moieties synthesized from intracellular sugar nucleotide precursors (Ganzle et al., 2005). However, biosynthesis process of both homo and hetero-exopolysaccharides differs from each other. Synthesis of homo-exopolysaccharide occurs through the enzymatic reactions of glucansucrase or levan sucrase by using sucrose (van Hijum et al., 2004), whereas, hetero-exopolysaccharide synthesis completes in four major steps involving sugar transportation, sugar nucleotide synthesis, repeating unit synthesis, and polymerization of the repeating units (de Vuyst and Degeest, 1999).
The most significant groups of lactic acid bacteria-derived exopolysaccharide are represented by α-glucans such as dextrans and mutans which are produced by L. mesenteroidesand S. mutans, respectively; whereas fructans such as levan are produced by S. salivarius (Cerning, 1990).
3. Chemical Composition and Chemical Structure: Mostly EPSs consist of carbohydrates and proteins but also contain DNA, lipids, humic substances, non-carbohydrate substituents (pyruvate, phosphate, acetate and succinate), amino sugars such as N-acetylamino sugars, neutral sugars (rhamnose etc) and some uronic acids (mainly galacturonic and glucuronic acids). Most bacterial EPSs consist of repeating units of different sizes and degrees of ramification. Some EPSs have irregular structures such as bacterial alginates (Mariam Zaheer et al., 2019). Their variability is enhanced by diversified configurations and glycosyl linkages (Ullrich, 2009). Bacterial EPSs might contain numerous pyruvate ketals and ester-linked substituents. These acyl groups give anionic properties to EPSs, increase their lipophilicity and also affect their capacity to act together with cations and other polysaccharides (Satyawali & Balakrishnan, 2009). EPS chemical composition deals with the detection of sugar residues, constituents of chain groups such as phosphate and acyl groups and sugar based repeating units. Anion- exchange chromatography at high pressure along with electrochemical or amperometric detection is currently used (Panagiotopoulos et al., 2001). Capillary electrophoresis for characterization of single carbohydrates can also be used (Gao et al., 2010).
a. Chemical Structure: EPSs have intricate chemical structures ranging from linear to highly branched heteropolysaccharides because of numerous combinations of sugar-based monomeric units. In the most recent method assessment of monomeric bonding pattern is done by conversion of EPSs into incompletely methylated alditol acetates that can be examined by GC-MS (Gas chromatography - mass spectrometry). The polysaccharides can be selectively fragmented by Smith degradation. Using linkage specific enzymes and nonspecific fractional acid hydrolysis, branching and molecular weight of EPSs can be decreased. Low molecular weight fragments are detected by GC-MS (Gas chromatography –mass spectrometry) and NMR (Nuclear magnetic resonance) spectroscopy (Hallack, et al., 2010). MALDI-TOF-MS (Matrixassisted laser desorption/ionization-time of flight mass spectrometry) also be used (Gauri et al., 2009.

4. At present four mechanisms have been recognized for bacterial EPSs’ Mechanisms of Biosynthesis of EPS in Bacteria: production: (i) The synthasedependent pathway (ii) The extracellular synthesis (iii) Wzx/Wzy-dependent pathway (iv)The ABC (ATP-binding cassette) transporter-dependent pathway (Donlan and Costerton, 2002 and Schmid et al., 2015).
a. Synthase Dependant Pathway: In this mechanism, complete polymer strand is secreted transversely to the cell membrane and the cell wall. After polymerization, synthase proteins translocate EPSs extracellularly. It is used for the production of homopolymers (Rehm, 2010).
b. The Extracellular Synthesis: This process is governed by glycosyltransferases, covalently attached to the surface of the cell and EPSs are secreted outside the cell. EPS, such as dextran or levan is synthesized (Czaczyk & Myszka, 2007).
c. Wzx/Wzy-dependent Pathway: In this pathway at the inner membrane, individual repeating units are attached to an undecaprenol diphosphate anchor (C55), arranged by sever46 glycosyltransferases and translocate across the cell membrane by a Wzx protein (flippase). At the periplasmic space, polymerization is done by flippase (Islam & Lam, 2014). The PCP (Polysaccharide co-polymerase) and OPX (Outer membrane polysaccharide exporters); formerly OMA (Outer membrane auxiliary) families help in translocation. Heteropolymers (e.g. xanthan) are synthesized by this pathway (Morona et al., 2009).
d. The ABC (ATP-binding cassette) Transporter-dependent Pathway: Capsular polysaccharide (CPS) is prepared by this pathway. CPS is attached to the cell surface. CPS is arranged at the inner membrane with the help of glycosyltransferases. Both heteropolymers and homopolymers are produced depending upon number of operons (GT–containing) involved (Whitney & Howell, 2013). A pump like composite (tripartite efflux) composed of PCP and OPX (periplasmatic proteins) and ABC-transporters help in translocation (Cuthbertson et al., 2009), closely related to secretion process of the Wzx/Wzy pathway. CPS formed has a glycolipid (poly-2-keto- 3-deoxyoctulosonic acid as a linker and phosphatidylglycerol at the reducing end). (Willis et al., 2013; Willis & Whitfield, 2013).

5. Biological activities of EPS: EPSs have been proved to show important health benefits like antioxidant (Kodali & Sen, 2008) cholesterol lowering (Welman & Mddox, 2003), antitumor (Hosono et al, 1997), antiviral and immunomodulatory activities (Arena et al., 2006). The reactive oxygen species (ROS) like) hydroxyl (OHÏ), superoxide (OÏ2 ), nitric oxide (NOÏ) etc. lead to various serious diseases including Parkinson’s disease, atherosclerosis, cancer, rheumatoid arthritis. EPSs have been proved to have antioxidant and free radical scavenging properties. The free radical scavenging property of EPSs can also be used to inhibit oxidation of vegetable oils. (Kishk et al., 2007) showed that the antioxidant and free radical scavenging activities of exopolysaccharide (RPS) isolated from Rhizobium meliloti and also showed the ability of RPS to inhibit lipid oxidation in sunflower oil emulsions during holding time for 50 h at 60°C. EPSs from probiotic bacteria show antiulcer activity. (Nagaoka et al., 1994) showed the anti-ulcer effects of bifidobacteria, lactobacilli and streptococci were examined using the acetic acid induced gastric ulcer and ethanol-induced erosion models in rats. Bifidobacterium breve YIT4014 and 4043, and Bifidobacterium bifidum YIT4007 were administered orally, and anti-ulcer effects were confirmed for not only these organisms but also their polysaccharide fractions (PSFs). The major component of these anti-ulcer polysaccharides was rhamnose. In particular, polysaccharides in which the rhamnose content exceeded 60% were more effective in healing gastric ulcers. It has been found that the EPSs stimulate the immune system and shown anticancer effects. Hosono et al., (1997) showed that polysaccharide from Bifidobacterium adolescentis M101-4 and showed that it is effective for stimulating the proliferation of murine splenocytes. Chabot et al (2001) isolated EPS from Lactobacillus rhamnosus RW- 9595M and tested in vitro for their possible modulating properties on mouse splenocytes from the C57Bl/6 and BALB/c strains, on the murine RAW 264.7 macrophage-like cell line and on human Peripheral Blood Mononuclear Cells (PBMC) and found that EPSs stimulate to synthesize TNF, IL-6 and IL-12 from the above cells.

6. Applications of EPS: EPSs are important in the formation of biofilm and attachment of cells to substrates. EPS is 50%-90% of entire organic matter of biofilm (Fleming, 2000). Biofilms are called symbolically dubbed microbial cities (Daegelen et al., 2009). EPSs produce resistance against host (non- specific and specific) during infection. They produce resistance to different antimicrobial agents, give protection against phagocytic protozoa and protect cyanobacterial nitrogenase against the detrimental effects of oxygen (Nwodo et al., 2012). It has been observed that a polymer group of sulfated polysaccharides has shown significant biological and functional properties (Ghosh et al., 2009). Since these sulfated polysaccharides as macromolecules display imitate patterns of sulfate substitution on glycosaminoglycans present in cell membranes, they have been found to be potent antiviral agents. Generally sulfated polysaccharides represent a complex polymer form of heterogeneous composition. Although chemical structure and activity relationship of sulfated polysaccharides have not been studied in detail, a number of these macromolecule even in crude forms have shown potent antiviral effect (Ghosh et al., 2009).


B. Biofilm formation by EPS
In nature, bacteria exists in colonies accumulating at interfaces to form poly-bacterial aggregates such as mats, flocs, sludge or biofilms and not planktonic dispersed single cells as will be seen in laboratory pure cultures (Flemming, H.C.; Wingender, J et al ., 2010). Bacteria are not alone in this endeavor as other microbes are inclusive.
However, our emphasis is with respect to bacteria and how their exopolysaccharides play crucial roles. Furthermore, for less ambiguity we will stick to the use of term biofilms to mean microbial aggregates that accumulate at a solid–liquid interface and are encased in a matrix of highly hydrated extracellular biopolymers. Although this description does not take into account groups of free floating microbial aggregates (flocs) ( Uchenchukwu U.Nwodo et al., 2012).
Biofilms have been metaphorically dubbed “city of microbes” (Daegelen, P. et al., 2009), and the extracellular biopolymers, in which exopolysaccharide predominates, as the “house of the biofilm cells” (Schembri, M.A. et al., 2004). Furthermore, Pseudomonas aeruginosa has been referred to as the Escherichia coli of biofilm research, because it is the most investigated bacteria with respect to biofilms research (Flemming, H.C. et al 2010).
Table 2: Some human disease associated with bacteria biofilms.
(Uchenchukwu U.Nwodo et al., 2012).
|
Human Disease |
Biofilm Bacteria |
|
Cystic fibrosis pneumonia |
P. aeruginosa and Burkholderia cepacia |
|
Otitis media |
Haemophilus influenzae (Non-typable strains) |
|
Periodontitis |
Gram negative anaerobic oral bacteria |
|
Dental caries |
Streptococcus spp. and other acidogenic Gram positive cocci |
|
Musculoskeletal infections |
Staphylococci and other Gram-positive cocci |
|
Necrotizing fasciitis |
Group A streptococci |
|
Bacterial prostatitis |
E. coli and other Gram-negative bacteria |
|
Urinary catheter cystitis |
E. coli and other Gram-negative rods |
|
Biliary tract infection |
E. coli and other enteric bacteria |
|
Meloidosis |
Pseudomonas pseudomallei |
2. Health benefits of EPS Biofilms: The EPS produced by probiotic bacteria have gained much importance in therapeutic applications such as antimicrobial, immunomodulatory, anti-inflammatory,antioxidant, anti-tumor, anti-viral, anti-diabetic, anti-ulcer and cholesterol lowering activities (A.Hussain et al., 2017, S. Patel et al., 2012).
a. Antimicrobial Activity: Several studies reports LAB are able to produce many antimicrobial compounds that include bacteriocins, diacetyl, organic acid, carbon dioxide and some other low molecular weight substances, such as reuterin, reutericyclin and antifungal peptides (S. Li et al., 2014).The EPS producing Lactobacillus rhamnosus isolated from human breast milk showed strong anti-bacterial activity against pathogenic E. coli and Salmonella typhimurium under in-vitro condition (M.S.Riaz Rajoka et al., 2018).
b. Immunomodulatory Activity: Various LAB and their extracellular polysaccharides were discovered to modulate the host immune system by boosting the proliferation of T/ B lymphocytes, natural killer (NK) cell tumoricidal activity, mononuclear cell phagocytic capacity, mitogenic activity, inducing cytokines and collectively increases the host immune defense against pathogen (L.Shao et al., 2014).
c. Anti-Inflammatory Activity: The microorganisms initiate in-flammation through endotoxin lipopolysaccharide (LPS) which targets Toll-like receptor-4 (TLR-4) to promote inflammatory gene expression (V.Toshchakov et al., 2002).LPS generates the production of mediators and cytokines such as nitric oxide (NO) and pro-inflflammatory cytokines like IL-1β, IL-6, and tumor necrosis factor (TNF-α) and suppress the secretion of anti-inflammatory cytokines such as IL-10 (M.Bhatia et al., 2004).
d. Antioxidant Activity: Reactive oxygen species (ROS) such as superoxide, hydroxyl radical, and hydrogen peroxide are produced from normal cellular metabolism responsible for severe ill-effects in humans, including cancer, atherosclerosis, rheumatoid arthritis, and neurodegenerative diseases(S.Li et al., 2014). The exopolysaccharides extracted from various probiotics were evaluated for their ability to exhibit antioxidant potential by the degradation of superoxide anion and hydrogen peroxide, reduction of ROS and metal chelating activity and it is desired to employ them as food supplement or in direct drug delivery system(C.F.Liu et al., 2010).
e. Anticancer Activity: The possible mechanisms of anticancer activity exerted by EPS are follows: (1) prevention of tumorigenesis, (2) induction of cancer cell apoptosis, and (improvement of the immunity. Apoptosis or programmed cell death is necessary in the treatment of cancer. It is characterized ) by caspase-dependent intrinsic and extrinsic pathways. The intrinsic pathway is indicated by the expression of caspase-3, caspase-9, BCl-2 and BAX, while, the extrinsic pathway is marked by the expression of caspase-8 and caspase-10. Among caspases, the caspase-8, caspase-9 and caspase-10 are initiators that are activated via binding to specific proteins; while caspase-3 is an effector caspase that is eventually activated by the active initiator caspases through photolytic cleavage (H. Zhao et al., 2019, H. Zhao et al., 2018).
f. Hypocholestrolemic Activity: The mechanisms behind cholesterol reduction by probiotic bacteria are as follows: (i) assimilation of cholesterol by growing bacterial cells, (ii) deconjugation of bile salts by bile salt hydrolase, (iii) precipitation of cholesterol with de-conjugated bile and (iv) binding of cholesterol to cells (M.G. Shehata et al., 2019). The EPS derived from Lactobacillus plantarum RJF4 was shown to reduce the cholesterol to 42.24%(S.V. Dilna et al., 2015).
g. Anti-viral activity: LAB exerts antiviral activities by various mechanisms like, direct interaction with viruses, production of viral inhibitory substances or by stimulation of immunity (I.Al Kassaa et al., 2014). Most important aspect is that sulfated polysaccharides are responsible for the antiviral effect even in crude form (J.Liu et al., 2009).
C. Objective
II. REVIEW OF LITERATURE
|
S.No |
AUTHOR |
YEAR |
TITLE |
SUMMARY |
|
1. |
I.G.Nwoso, et al. |
2019 |
Isolation, Screening and Characterization of Exopolysaccharide producing bacteria.
|
A study on the isolation and screening of exopolysaccharides from soil and extreme environment.
|
|
2. |
Mu minah, et al. |
2015 |
Isolation, Screening of exopolysaccharide producing bacteria from potato rhizosphere for soil aggregation.
|
Explicated on the isolation of EPS producing isaoltes from various altitudes of different land slopes and their production ability.
|
|
3. |
Muthuswamy Govarthanan, et al.
|
2015 |
Isolation of exopolysaccharide producing heavy metal resistant Halomonas sp. MG.
|
An article on the isolation of Halomonas from ore taminated soil.Various techniques employes such as X-ray diffractograms. SEM,FTIR for structural analysis of EPS. |
|
4. |
Vivek K. Bajpai, et al. |
2015 |
Exopolysaccharide and lactic acid bacteria: Perception, functionality and prospects
|
The study on the EPS production abilities of lactic acid bacteria.It provides review about the properties, characterization and biological tailoring of EPS production. |
|
5. |
K.V. Madhuri, K. Vidya Prabhakar
|
2014 |
Microbial exopolysaccharides: Biosynthesis and Potential Applications.
|
A review on various therapeutic applications of EPS producing lactic acid bacteria and microbial mechanisms for synthesis of EPSs.
|
|
6. |
Madhuri K.V , Prabhakar K.V
|
2014 |
Recent trends in the characterization of Microbial polysaccharides.
|
The study on detecting biochemical properties of EPS and also the monomeric composition.
|
|
7. |
Pawar,S.T, et al. |
2014 |
Isolation,Screening,Optimization of exopolysaacharides producing bacterium from saline soil. |
An article on isolation of EPS producing bacterium from saline soil,yield determination along with preferred carbon source. |
|
8. |
Tejpreet Chadha |
2014 |
Bacterial Biofilms: Survival Mechanisms and Antibiotic Resistance
|
An article on understanding intercellular communications within biofilms and the mechanisms of their formation. |
|
9. |
Tiehua Zhang, et al. |
2011 |
Growth and Exopolysaccharide production by Streptococcus thermophilus in skim milk. |
Demonstrated the production potential of EPS from Streptococcus thermophilus with skim milk under varying concentrations,pH, carbon sources |
|
10. |
J.Cerning, et al. |
1994 |
Carbon source requirement for exopolysaccharide production by Lactobacillus casei CG11 and partial structure analysis of polymer. |
The work mainly focused on the EPS production from Lactobacillus casei using various carbon sources in the basal medium.
|
III. MATERIALS AND METHODS
A. Sample Collection
Garden soil sample was collected from St.Francis College for Women and oil contaminated soil , Uppal for this study. The samples were collected and transferred into sterile containers and taken into laboratory for further study.
B. Isolation of EPS Producing Bacteria
The EPS producing bacteria were isolated from the soil samples following the serial dilution technique (Waksman,1922). Serial dilutions up to 10-6 was made. 0.1 ml of diluent suspension is inoculated on to the Nutrient agar and Bushnell-Haas agar supplemented with 2% sucrose as carbon source and incubated at 37? for 24 hours.
5 different colonies were selected for the further screening.
C. Screening for EPS Production
24hours old cultures of the selected isolates from the samples were inoculated into the nutrient broth supplemented with 2% sucrose in 250ml flask. The flasks were incubated in rotary shaker for 3days,120rpm at 30?. Cell free supernatant (6000rpm,10mins) was precipitated overnight with two volumes of cold ethanol at 4? (Manel Ziadi et al., 2018). Precipitates of EPS were collected after centrifuging at 10,000rpm for 20mins and later dried at 60? overnight in the hot air oven.
( I.G Nwoso et al., 2019).
D. Characterization of Bacteria (Prescott, 2002)
The selected bacterial isolates were identified by morphological tests and biochemical tests.
a. Gram Staining:The bacterial isolates were identified by the gram-staining method to determine the gram character according to the Prescott,2002. Based on the nature of cell wall of bacteria they are classified into Gram positive or Gram negative.
b. Endospore Staining: Spore staining is carried out for the detection of endospores in the bacterial isolates according to Prescott,2002. The heat-fixed smeras were stained with malachite green and steamed followed by counter staining with safranin. Upon microscopic observation, the vegetative cells appear pink and endospores appear green. Some of the spore staining techniques include Shaeffer-Fulton and Moeller staining.
2. Biochemical Tests: The EPS producing isolates were further identified by the series of IMViC tests, Catalase and Oxidase tests performed for the identification of organisms.
a. Indole Test: The test is carried out in either Sulfide-motility(SIM) medium or in tryptophan broth. It is used to detect the ability of bacterial isolates to decompose the amino acid tryptophan to indole in the presence of tryptophanase enzyme. The loop full of 24hrs old culture of isolates were inoculated in the tryptone broth and incubated at 37? for 24hrs . After incubation the tubes were checked after the addition of Kovac’s reagent and the results were noted down.
b. Methyl Red (MR) Test: Methyl red test is carried out in Methyl Red - Voges Proskaeur(MR-VP) broth.The MR test is used to detect the ability of bacterial isolates to produce acids which results in lowering of pH which in turn detected by methyl red reagent added. The loop full of 24hrs old culture of isolates were inoculated in the MR-VP broth and incubated at 37? for 24hrs . After incubation the tubes were checked after the addition of Methyl red reagent and the results were noted down.
c. Voges-Proskaeur (VP) Test: Voges-Proskaeur test is carried out in Methyl red-Voges Proskaeur(MR-VP) broth.The test is used to determine the production of acetylmethyl carbinol from glucose fermentation. The loop full of 24hrs old culture of isolates were inoculated in the MR-VP broth and incubated at 37? for 24hrs . After incubation the tubes were checked after the addition of Barritts’A followed by Barritt’s B reagent and the results were noted down.
d. Citrate Utilization Test: The test was performed on the Simmon’s Citrate agar. The test was carried out to detect the production of enzyme ‘citrase’ by the bacterial isolates. Inoculum from the bacterial isolates are streaked on the surface of agar and incubated for 3-5 days at 37?. Change in the color and growth observed on the slants were detected.
e. Catalase Test (Slide Method): The test was performed to detect the presence of enzyme catalase. The loop full of 24hrs old culture of isolates were added on to the slide with 3% of hydrogen peroxide. Positive result is indicated by the evolution of oxygen bubbles.
f. Oxidase Test: The test was performed to detect the presence of enzyme of cytochrome c oxidase. The loop full of 24hrs old culture of isolates were added on to the oxidase paper disc. The positive result was indicated by the formation of purple colour within 10 seconds.
g. Sugar Fermentation Tests: Sugar fermentation tests are used to detect the fermentation of sugars by the bacterial isolates according to Prescott,2002. Specific carbohydrates such as Glucose, Lactose, Fructose, Sucrose, Maltose, Mannitol and Xylose are taken in concentration of 1% to detect the fermentation of carbohydrates by micro-organisms. Phenol-red indicator is used as pH indicator. Change in the color occurs due to the lowering of pH due to acid production. Later, durham tubes are introduced upside down in to the tubes for the detection of gas production. 24hours culture of bacterial isolates are inoculated with the carbohydrates and incubated for 24 hours at 37?. The positive result was indicated by the development of yellow and the gas bubbles in the durham tubes due to the acid production and lowered pH. The negative result was indicated by no color development in the tubes.
E. Quantitative estimation of carbohydrate content of EPS by Phenol-Sulphuric acid Method
The quantitative estimation of glucose concentration in precipitates of EPS was determined by Phenol-Sulphuric acid method (Dubois et al., 1956).
The precipitated EPS obtained in the screening step is made up to 200µl with distilled water. 0.2ml of 5% phenol solution is added to all the tubes along with 1ml of concentrated sulphuric acid . Vortex the tubes for uniform mixing. All the tubes were allowed to stand for 60 minutes.
Initially, colorimeter is set at 490nm wavelength range and absorbance of the control with distilled water is taken and made to zero. Later absorbance readings of all the tubes were taken at 490nm. The concentration of glucose of the EPS was determined from the standard graph.
F. Effect of Carbon Sources on the EPS Production
The effect of different carbon sources on the EPS production by bacterial isolates was detected (J.Cerning et al., 1994). The effect of different carbon substrates such as Glucose, Maltose, Lactose and Sucrose at varying concentrations of 1% and 2% was determined.
The EPS producing strains were inoculated into tubes containing nutrient broth with varied concentration of carbon substrates. The isolates were incubated for 24hours at 37?. After 24 hours, the absorbance was measured by the colorimeter at 600nm. The best utilizable carbon substrate and the concentration by EPS producing bacteria was determined.
G. In-vitro Antibiotic Susceptibility of EPS and Non-EPS Strains
In-vitro antibiotic susceptibility of EPS and Non-EPS isolates was determined for the EPS producing isolates by the multiple disc-diffusion method (W.M.M Kirby et al., 1959). The multiple disc-diffusion method was used to determine the susceptibility of bacterial isolates towards the antimicrobial agents. The antibiotics used for the study were, viz. Amikacin (AK), 30mcg; Ampiclox (ACX), 20mcg; Ciprofloxacin (CIP), 5mcg; Clarithromycin (CLR), 15mcg; Cefotaxime (CF), 30mcg; Sparfloxacin (SF), 5mcg; Cefuroxime (CR), 30mcg; Cefoperazone (CFP), 75mcg; Gentamicin (G), 10mcg; Roxythromycin (RX), 15mcg; Cefadroil (CD), 30mcg; Azithromycin (AZ), 15mcg; Slubactum (SLB), 20mcg; Ceftriaxone (CTX), 30mcg; Netilmicin (NET), 30mcg; Ceftazidime (CF), 30mcg; Moxifloxacin (MF), 5mcg; Cotrimoxazole (BA), 25mcg; Piperacillin (PIT),110mcg. The zone of inhibition diameter is measured by using scale or sliding caliper. The measured zone of diameter is compared with the standard chart to detect the susceptible, intermediate and resistant values. The test was performed by the inoculation of 18-24 hours old culture of bacterial isolates which needs to be tested for their susceptibilty towards antibiotics. The procedure involves the preparation of sterilized Mueller-Hinton agar and was poured into the petri plate and allowed to solidify. Freshly prepared 0.1ml of 24 hour culture suspension of bacterial isolate was inoculated on to the Mueller-Hinton agar.The axiom multi discs antibiotics was placed on the agar surface. The plates were incubated at 37? for 18-24 hours. The antibiotic susceptibility was determined by the formation of zone of inhibition around the antibiotic discs.
IV. RESULTS AND DISCUSSION
A. Isolation of EPS Producing Bacteria
The EPS producing bacteria was isolated using garden soil and oil contaminated soil samples and were inoculated on Nutrient and Bushnell-Haas media supplemented with 2% sucrose and incubated as shown in the Fig 4.1. After 24 hours incubation, 5 different colonies were observed after the incubation period. They were both mucoid and non-mucoid colonies and were labelled as A, B - Non-mucoid colonies. C, D and E - Mucoid colonies. These 5 isolates were selected for further screening and characterization of bacteria.
B. Screening for EPS Production
The bacterial isolates selected were inoculated into nutrient broth with 2% sucrose and subjected to rotary shaker treatment. All the isolates were treated with alcohol for precipitation,it was observed that 2 bacterial isolates i.e, Lactobacillus and Pseudomonas produced significant amounts of precipitates of EPS after overnight drying in the hot air oven. The dry weight of precipitates of EPS of 2 isolates were determined. ( I.G Nwoso et al., 2019) as shown in the Fig 4.3b.
The dry weight of precipitates of EPS from Lactobacillus isolate was determined to be 0.09g and Pseudomonas isolate to be 0.17g. The precipiate of EPS obtained from the Pseudomonas isolate was greater when compared to EPS dry weight produced by the Lactobacillus isolate.

C. Characterization of Bacteria (Prescott, 2002)
Table 3: Morphological identification of selected bacterial isolates
|
Bacterial Isolate |
Dilution |
Colony Characteristics |
Field view |
|
A |
10-6 Nutrient agar (Garden soil) |
Circular,small,entire, flat,dry,white,opaque
|
Gram positive cocci |
|
B |
10-1 BH Agar (Garden soil) |
Circular,small,entire,flat,dry, white,opaque
|
Gram negative rods |
|
C |
10-5 Nutrient agar (Oil contaminated soil) |
Irregular,small,entire,raised, moist,white,opaque. |
Gram positive cocci |
|
D |
10-6 Nutrient agar (Garden soil) |
Irregular,small,entire,raised, moist,white,opaque |
Gram positive rods |
|
E |
10-4 Nutrient agar (Oil contaminated soil) |
Circular,large,entire,raised, moist,white,opaque
|
Gram negative rods |
a. Gram Staining

b. Endospore Staining

2. Biochemical tests (Prescott, 2002): The EPS producing bacterial isolates were further identified by the biochemical tests as seen in the Table 4. The indole test was determined for both the EPS producing isolates as negative as cherry ring was absent as a top layer after the addition of kovac’s reagent which indicates the absence of tryptophanase enzyme in both the isolates as seen in Fig 4.4.2a. The Methyl red test was negative for both the isolates indicating the absence of acid production by isolates which was indicated by no color change in the broth as seen in Fig 4.4.2 b. The Voges proskaeur test was negative after the addition of Barritts’A and Barritt’s B reagent for both EPS isolates which indicates the absence of formation of acetyl methyl carbinol as seen Fig 4.4.2 c.
The Citrate utilization test was negative for ‘D’ EPS isolate due to the absence of citrase enzyme and no color change (green) was observed. For the E isolate it was positive due to the change in color (blue) and growth observed on the citrate agar slant which indicates the presence of citrase enzyme as seen in Fig 4.4.2 d. The Catalase test was negative for D isolate as no gas bubbles were evolved due to the absence of catalase enzyme. For the E isolate the catalase test was positive due to the oxygen evolution and the presence of enzyme as seen in Fig 4.4.2 e. The Oxidase test was negative for the D isolate as no purple spot was observed after inoculating the culture on to the oxidase disc. The E isolate oxidase test was positive due to the formation of purple spot after the addition of culture on to the disc. This is due to the presence of enzyme cytochrome c oxidase as seen in Fig 4.4.2 f.

a. Sugar Fermentation Tests: The sugar fermentation tests were carried out for EPS producing isolates (Prescott,2002). The bacterial isolates were incubated with sugars and phenol-red indicator for 24hrs at 37?. After the incubation change in color and gas bubbles presence in the durham’s tubes were observed as shown in Table 5. The D isolate was positive for sugar fermentations of Glucose, Fructose, Lactose, Maltose, Sucrose, Mannitol which was indicated by the formation of yellow color due the acid production and negative for Xylose, indicated by no color change. The E isolate was positive for sugar fermentations of Mannitol, Sucrose and Xylose indicated by color change(yellow) and negative for the sugars Glucose, Fructose, Lactose, Maltose. Following the Bergey’s manual of systematic bacteriology, the EPS producing bacterial isolates (D, E) were identified to be Lactobacillus sps and Pesudomonas sps respectively.

D. Quantitative estimation of carbohydrate content of EPS by Phenol-Sulphuric acid Method
The Phenol-Supluric acid method was used to determine the carbohydrate content of the EPS. The concentration of carbohydrate content in the precipitates of EPS was determined (Dubois et al., 1956) which were produced by Lactobacillus and Pseudomonas isolates. The absorbance was measured at 490nm as seen in Fig 4.5 a
From the standard graph, glucose concentration of precipitates of EPS obtained from the isolates were determined as shown in Fig 4.5 b. Concentration of sugar in EPS sample of Lactobacillus sps was determined to be 22.5 µg/200µl. Concentration of sugar in EPS sample of Pseudomonas sps was determined to be 57.5µg/200µl.
The concentration of carbohydrate in the Pseudomonas sps. isolate was greater when compared to the carbohydrate content present in the Eps precipitate of Lactobacillus sps. isolate.

A standard glucose graph was constructed.

E. Effect of Carbon Sources on EPS Production
The effect of various carbon substrates on EPS producing isolates were determined (J.Cerning et al., 1994). The EPS producing isolates (Lactobacillus sps, Pseudomonas sps) were incubated for 24hrs with different carbon substrates and concentrations. After 24 hrs the absorbance readings of the EPS strains were recorded colorimetrically at the wavelength range of 600nm.
Lactobacillus sps strain was grown in the presence of 4 sugars at 1% and 2% concentrations. It was observed that it grows significantly when provided with sucrose and lactose but grows more efficiently when provided with the sucrose at 2% concentration as seen in Fig 4.6 a.
Pseudomonas sps strain was grown in the presence of 4 sugars at 1% and 2% concentrations. It was observed that it grows significantly when provided with sucrose and glucose but grows more efficiently when provided with the sucrose at 2% concentration as shown in Fig 4.6 b.
Table 6: Carbon sources employed for EPS producing isolates
|
Bacterial isolate |
OD at 600nm |
|||||||
|
Maltose 1% |
Maltose 2% |
Glucose 1% |
Glucose 2% |
Sucrose 1% |
Sucrose 2% |
Lactose 1% |
Lactose 2% |
|
|
Lactobacillus sps |
0.24 |
0.3 |
0.34 |
0.42 |
0.56 |
0.67 |
0.21 |
0.28 |
|
Pseudomonas sps |
0.3 |
0.36 |
0.38 |
0.53 |
0.81 |
1.1 |
0.32 |
0.39 |

F. In-vitro Antibiotic Susceptibility of EPS and Non-EPS Strains
The antibiotic susceptibility of 5 bacterial isolates were determined and the zones of inhibition were observed(W.M.M. Kirby et al., 1959)
The bacterial isolate A was found to be sensitive towards Clarithromycin (15mcg) and resistant towards Amikacin (30mcg), Gentamicin (10mcg) and Ciprofloxacin (5mcg). It was found to be intermediate for Sparfloxacin (5mcg) as seen in Table 7.
The bacterial isolate B was found to be sensitive towards Ceftazidime (30mcg) and Gentamicin (10mcg).It was intermediate for Amikacin (30mcg), Slubactum (20mcg), Netilmicin (30mcg) and Cotrimoxazole (25mcg). It was resistant towards Ciprofloxacin (5mcg), Cefotaxime (20mcg) and Moxifloxacin (5mcg) as seen in
Table 7. The bacterial isolate C was intermediate towards Amikacin (30mcg) and Cefotaxime (2mcg) as shown in Table 7. The EPS producing Lactobacillus sps was found to be resistant towards all the antibiotics as shown in Table 7. The EPS producing Pseudomonas sps was found to be resistant towards all the antibiotics as shown in Table 7. The Non-EPS isolates (A, B and C) were found to be more sensitive towards the antibiotics with larger zones of inhibition i.e, due to the absence of EPS protective layer around cell wall as shown in Fig 4.7 (a-c). The EPS isolates (D and E) were found to be more resistant towards antimicrobial agents due to the presence of EPS protective layer as seen in Fig 4.7 (d,e).
In the comparison, bacterial isolate B and EPS producing Pseudomonas sps were compared. The Non-EPS isolate B produced zones of inhibition with bigger diameter when compared to the EPS producing Pseudomonas with small zones of inhibition due to the presence of exopolysaccharide outside the cell wall as seen in the Fig 4.7 (f).


V. DISCUSSION
Microbial exopolysaccharides are biopolymers secreted by microbial cells as loosely bound slime in association with the cell surface (Freitas F, et al., 2011). Previous studies showed that the quantities and composition of microbial EPS depends on species of organism isolated and its cultural conditions (Donot F, et al., 2012). In the present study, the EPS producing isolates were isolated from soil samples which was similar to the work conducted by I.G. Nwoso et al., 2019 in which 34 EPS isolates were identified. The screening for the presence of EPS production was carried out by the alcohol precipitation and dry weights were determined of Lactobacillus sps and Pseudomonas sps which was also carried out by the study of Tudor and others where L.mesenteroides produced the maximum dry weight when measured. The quantitaive estimation of carbohydrate content of EPS precipitates were carried out which was also carried out by the I.G. Nwoso et al., 2019.
Later, the effect of various carbon substrates on the EPS production was determined. The sucrose carbon source at 2% concentration was found to be the most utilizable carbon source by the two EPS producing isolates. Pawar and others optimized EPS production of bacterial isolates with different concentrations of sucrose and reported that maximum production was obtained at the concentration of 2% (Pawar ST, et al., 2017). The antibiotic sensitivity of EPS and Non-EPS isolates was carried out. It was determined that EPS producing Lactobacillus sps and Pseudomonas sps were resistant to antimicrobial agents which was similar to the work done by Hui Jin et al., 2019 where antibiotic sensitivity was carried out on the different species of Lactobacillus and considered for use in food industry based on antibiotic analyses.
The EPS producing bacteria were isolated from the garden and oil contaminated soil samples. Selected bacterial isolates were screened for the presence of EPS by subjecting to alcohol precipitation and the dry weights were determined. The bacterial isolate Lactobacillus sps produced less dry weight of EPS than the isolate Pseudomonas sps. The carbohydrate content of EPS precipitate of Lactobacillus sps was found to be lesser than the Pseudomonas sps. The antibiotic susceptibility of the EPS isolates was tested, Lactobacillus sps and Pseudomonas sps were found to be resistant towards the antibiotics than the non-EPS isolates The presence of exopolysaccharide layer around the cell walls of these EPS isolates was responsible for the protection against the antibiotics.
[1] A. Hussain, K.M. Zia, S. Tabasum, A. Noreen, M. Ali, R. Iqbal, M. Zuber.(2017). Blends and composites of exopolysaccharides; properties and applications: a review, Int. J. Biol. Macromol. 94 . 10–27. [2] Ahmed RZ, Siddiqui K, Arman M, Ahmed N.(2012). Characterization of high molecular weight dextran produced by Weissella cibaria CMGDEX3. Carbohyd Polym. ;90:441–6. [3] Bouzar F, Cerning J, Desmazeaud M. (1996).Exopolysaccharide production in milk by Lactobacillus delbrueckii subsp. bulgaricusCNRZ 1187 and by two colonial variants.Journal of Dairy Science; 79: 205-211. [4] Cerning J, Bouillanne C, Desmazeaud MJ,Landon M. (1986). Isolation and characterization of exocellular polysaccharide produced by Lactobacillus bulgaricus. Biotechnology Letters; 8: 625-628. [5] Cerning J. (1995). Production of exopolysaccharides by lactic acid bacteria and dairy propionibacteria. Le Lait Diary Science and Technology; 75: 463-472.7. [6] Cho EJ, Oh JY, Chang HY, Yun JW. (2006). Production of exopolysaccharides by submergedmycelial culture of a mushroom Tremellafuciformis. Journal of Biotechnology; 127:129–140. [7] Clementi, F., Fantozzi, P., Mancini, F. and Moresi, M., (1995). Optimal conditions for alginate production by Azotobacter vinelandii. Enzyme Microbial. Technol. 17(11): 983- 988. [8] De Vuyst L, Degeest B. (1999). Heteropolysaccharides from lactic acid bacteria.FEMS Microbiology Reviews ; 23: 153-177. [9] Degeest B, De Vuyst L. (1999). Indication that the Nitrogen Source Influences Both Amount and Size of Exopolysaccharides Produced by Streptococcus thermophilus LY03 and Modelling of the Bacterial Growth and Exopolysaccharide Production in a Complex Medium. Applied and Environmental Microbiology ; 65: 2863-2870 [10] Di Cagno R, De Angelis M, Limitone A, Minervini F, Carnevali P, Corsetti A, Gaenzle M, Ciati R, Gobbetti M.(2006). Glucan and fructan production by sour dough Weissella cibaria and Lactobacillus plantarum. J Agric Food Chem. ;54:9873–81 [11] Dubois M, Gilles KA, Hamilton JK, PebersPA, Smith F. (1956). Colorimetric method fordetermination of sugar and relatedsubstances. Analytical Chemistry ; 28:350–356. [12] Farres, J., Caminal, G. and Lopez-Santin, J., (1997). Influence of phosphate on rhamnosecontaining exopolysaccharide rheology and production by Klebsiella I-714. Appl.Microbiol. Biotechnol. 48(4): 522-527. [13] Geresh S, Adin I, Yarmolinsky E, Karpasas M. (2002). Characterization of extra cellularpolysaccharide of Porphyridium sp.:molecular weight determination andrheological properties. Carbohydratepolymers ; 50: 183-189. [14] Germond JE, Delley M, D Amico N, Vincent SJ. (2001). Heterologous expression andcharacterization of the exopolysaccharide from Streptococcus thermophilus Sfi39.European Journal of Biochemistry ; 268:5149–5156. [15] Gu D, Jao Y, Wu J, Liu Z, Chen Q (2017). Optimization of EPS production and characterization by a halophilic bacterium, Kocuria rosea ZJUQH from Chaka salt lake with response surface methodology. Molecules. ;22:814. [16] H. Zhao, X. Xu, S. Lei, D. Shao, C. Jiang, J. Shi, Y. Zhang, L. Liu, S. Lei, H. Sun, Q. Huang.(2019).Iturin A-like lipopeptides from Bacillus subtilis trigger apoptosis, paraptosis, and autophagy in Caco-2 cells, J. Cell. Physiol. 234 .6414–6427 [17] influencing the production and recovery of microbial polysaccharides. [18] Jindal N, Singh DP, Khattar JIS (2011). Kinetics and physico-chemical characterization of exopolysaccharides produced by the cyanobacterium Oscillatoria formosa. World Journal of Microbiology and Biotechnology ;27:2139-2146. [19] Kaur V, Bera MB, Panesar PS, Chopra HK. (2013). Production and characterization of exopolysaccharide produced by Alcaligenes faecalis B14 isolated from indigenous soil. International Journal of Biotechnology and Bioengineering Research ;4(4):365-374. [20] L. De Vuyst, F. De Vin, F. Vaningelgem, B. Degeest.(2001). Recent developments in the biosynthesis and applications of heteropolysaccharides from lactic acid bacteria, Int. Dairy J. 11 . 687–707 [21] L. Xiu, H. Zhang, Z. Hu, Y. Liang, S. Guo, M. Yang, R. Du, X. Wang.(2018). Immunostimulatory activity of exopolysaccharides from probiotic lactobacillus casei WXD030 strain as a novel adjuvant in vitro and in vivo, Food Agric. Immunol.29. 1086–1105. [22] Liu C, Lu J, Liu Y, Wang F, Xiao M. (2010). Isolation, structural characterization and immunological activity of an exopolysaccharide produced by Bacillus licheniformis 837-0-1. Bioresources Technology ;101:5528-5533. [23] M. Ziadi, T. Bouzaiene, S. M’Hir, K. Zaafouri, F. Mokhtar, M. Hamdi, C. BoissetHelbert.(2018). Evaluation of the effificiency of ethanol precipitation and ultrafifiltration on the purifification and characteristics of exopolysaccharides produced by three lactic acid bacteria, Biomed. Res. Int. 2018. [24] Morin, A., 1998. Screening of polysaccharideproducing microorganisms, factors [25] Muminah Baharuddin, Subair H, Fahruddin, Darwisah B. ( 2015). Isolation and screening of exopolysaccharide producing bacteria (EPS) from potato rhizosphere for soil aggregation. International Journal of Current Microbiology and Applied Sciences ;4(6):341-349. [26] Nwodo UU, Green E, Okoh AI. (2012). Bacterial exopolysaccharides: Functionality and prospects. International Journal of Molecular Science ;13:14002-14015. [27] Nwoso I.G,Abu G,Agwa K.O. (2019). Isolation,Screnning and Characterization of Exopolysaccharide Producing Bacteria. Microbiology Research Journal International ; 29(5) ; 1-9. [28] Poli A, Anzelmo G, Nicolaus B. (2010). Bacterial exopolysaccharides from extreme marine habitats: Production, characterization and biological activities. Marine Drugs ;8:1779-1802. [29] R. Parveen, M. Anandharaj, A. David.(2018). International journal of biological macromolecules characterization of a novel exopolysaccharide produced by Lactobacillus gasseri FR4 and demonstration of its in vitro biological properties, Int. J. Biol. Macromol. 109 . 772–783, [30] S. Patel, A. Majumder, A. Goyal.(2012). Potentials of exopolysaccharides from lactic acid Bacteria, Indian J. Microbiol. 52 . 3–12. [31] S.V. Dilna, H. Surya, R.G. Aswathy, K.K. Varsha, D.N. Sakthikumar, A. Pandey, K.M. Nampoothiri.(2015). Characterization of an exopolysaccharide with potential healthbenefifit properties from a probiotic Lactobacillus plantarum RJF4, LWT - Food Sci.Technol. 64 . 1179–1186. [32] Schmid, J., Sieber, V. and Rehm, B., (2015). Bacterial exopolysaccharides: biosynthesis pathways and engineering strategies. Front. Microbiol. 6: 496. [33] Shukla V, Patel M, Duggirala. (2015). Isolation, structural characterization and production of exopolysaccharide producing batch culture of Bacillus species isolated from the soil. International Journal of Research in Engineering and Applied Sciences ;3(2):102-109. [34] Singha TK. (2012). Molecular extracellular polymeric substances. Production, isolation and application. IOSR Journal of Pharmacy ;2(2):276-281. [35] Subair, H. (2015). Isolation and Screening Bacterial Exopolysaccharide (EPS) from Potato Rhizosphere in Highland and the Potential as a Producer Indole Acetic Acid (IAA). Procedia. Food. Sci. 3: 74-81. [36] Sutherland JW. (2002). Biopolymer polysaccharides from prokaryotes. In: Vandamme EJ, De Baet S, Steinbuchet B. Ed. ;5:1-19. [37] Sutherland, I.W. (1972). Bacterial exopolysaccharides. Adv. Microb. Physiol. 8: 143-213. Academic Press. [38] T. Sungur, B. Aslim, C. Karaaslan, B. Aktas. (2017). Anaerobe impact of exopolysaccharides (EPSs) of Lactobacillus gasseri strains isolated from human vagina on cervical tumor cells (HeLa), Anaerobe 47. 137–144. [39] Toba, T., Nakajima, H., Tobitani, A. and Adachi, S., (1990). Scanning electron microscopic and texture studies on characteristic consistency of Nordic ropy sour milk. Int. J. food Microbiol. 11(3): 313-320. [40] van Kranenburg R, Boels IC, Kleerebezem M, de Vos WM.(1999). Genetics and engineering of microbial exopolysaccharides for food: Approaches for the production of existing and novel polysaccharides. Curr Opin Biotechnol. ; 10: 498- 504. [41] Vasanthakumari DS, Harikumar S, Beena DJ, Pandey A, Nampoothiri KM.(2015). Physicochemical characterization of an exopolysaccharide pro duced by a newly isolated Weissella cibaria. Appl Biochem Biotechnol. ;176:440–53 [42] Vijayabaskar P, Babinastarlin S, Shankar T, Sivakumar T, Anandapandian KTK. (2011). Quantification and characterization of exopolysaccharides from Bacillus subtilis (MTCC 121). Advances in Biological Research ;5(2):71-74. [43] Vijayendra SVN, Babu SRS.(2008). Optimization of a new heteropolysaccharide production by a native isolate of Leuconostoc sp. CFR-2181. Lett Appl Microbiol. ; 46: 643-48. [44] Vinderola G, Perdigon G, Duarte J, Famworth E, Matar C. (2006). Effects of the oral administration of the exopolysaccharide produced by Lactobacillus kefiranofacienson the gut mucosal immunity. Cytokine ; 36: 254-60. [45] Whitney, J.C. and Howell, P.L. (2013). Synthasedependent exopolysaccharide secretion in Gram-negative bacteria. Trends Microbiol. 21: 63-72.
Copyright © 2022 Sudha Sree, Ms. V. Gayatri. This is an open access article distributed under the Creative Commons Attribution License, which permits unrestricted use, distribution, and reproduction in any medium, provided the original work is properly cited.
Paper Id : IJRASET39341
Publish Date : 2021-12-09
ISSN : 2321-9653
Publisher Name : IJRASET
DOI Link : Click Here
Submit Paper Online
